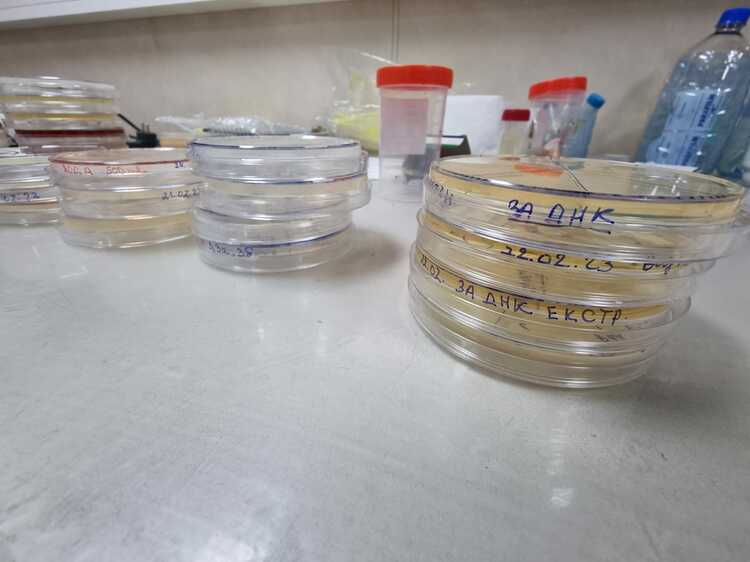

Учени откриха хиляди непознати микроби от океански зони като Марианската падина, съобщи Сайънс алърт. Анализирането на техните методи за оцеляване може да даде на биолозите цял нов набор от ресурси, които да използват във всичко – от медицина до еволюционни изследвания.
Само 6 км мътна вода разделят океанската повърхност от най-дълбоките части на океана, наречени хадална зона. Тя обаче е съвсем различен свят, който се спуска на дълбочина до 11 км. В нея прониква по-малко от 1 процент слънчева светлина и фотосинтезата е невъзможна.
Китайски изследователи са се спуснали 33 пъти с пилотирана подводница в хадалната зона и са взели проби от седимент и морска вода. Последващият анализ идентифицира 7564 вида микроби, от които почти 90 процента са нови за науката.
„Нашето изследване се фокусира върху дългогодишна цел в микробната екология – изясняване на това как средата оформя микробните общности, особено при екстремни условия“, пишат изследователите в сп. „Сел“.
Температурите в хадалната зона са близки до точката на замръзване, налягането на водата е огромно и има много малко хранителни вещества. Като се има предвид това, разнообразието от видове е изненадващо.
Микробите, открити от изследователите, обикновено прилагат една от двете стратегии за оцеляване. Някои имат по-малки, по-прости геноми, еволюирали за ефективен живот. Тези микроби показаха данни за ензими, предназначени да устоят на стреса от живота на такива дълбочини.
Други микроби имат по-големи геноми – създадени не за ефективност, а за гъвкавост. Това ги прави по-способни да се адаптират към натиска на околната среда и да могат да оцелеят от по-широк набор от вещества за препитание.
„Изключително голяма новост, разнообразие и хетерогенност се наблюдават в хадалния микробиом, особено сред прокариотите и вирусите, които са повлияни както от по-широкия контекст на екстремни условия на околната среда, така и от деликатната топография в хадаловата зона“, отбелязват изследователи в редакционна статия.
Микробите обикновено намират подходящи кътчета и пролуки в дълбините на океана и се придържат към тях. Всяко от местата, от които са взети проби, има своя специфична комбинация от микроби, с малко припокриване между тях.
На по-големи дълбочини сътрудничеството изглежда е по-важно за оцеляването на микробите, като тези малки организми споделят хранителни вещества и показват поведение, което е от полза за общността като цяло (включително образуване на защитни биофилми).
Изследователският екип направи своите открития достъпни онлайн, за да могат други учени да работят с тях под заглавието на проекта за изследване на околната среда и екологията на Марианската падина (MEER) и да обогатят знанията за това как животът оцелява в екстремни условия Това дава нови възможности за изследване в биотехнологиите.
Наши спонсори са:
Български трактори на добри цени при изключително качество